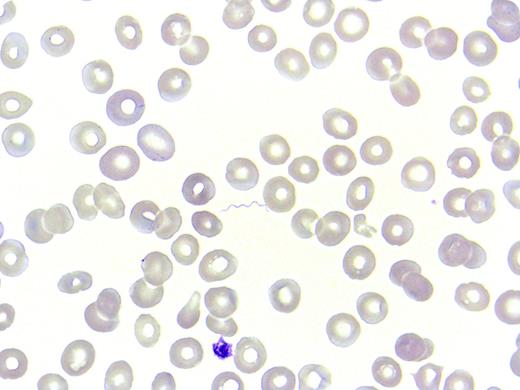
A 17-year-old refugee from Eritrea presented with sudden fever (to 41°C), myalgias, and headache. Three days before admission, he had arrived in Switzerland after a long journey through the Sudan and Libya and across the Mediterranean and Italy. Other than mild anemia, he had unremarkable blood values (hemoglobin, 122 g/L; white blood cells, 5.6 × 109/L; platelets, 187 × 109/L) and an increased C-reactive protein of 55 mg/L. No localizing infection was found by clinical examination, chest radiograph, or urine analysis. During a search for malaria, spirochetes were spotted in the blood film (Giemsa stained, original magnification ×100). Given the travel history and clinical symptoms, louse-borne relapsing fever (LBRF) was diagnosed, caused by Borrelia recurrentis. A treatment with doxycycline for 7 days was effective. / B recurrentis is transmitted by human body lice and is endemic in the highlands of eastern Africa, southern Sudan, and the Andean foothills. The disease occurs typically in overcrowded areas and in situations with reduced hygiene like war and mass migration. In recent months, an increasing number of cases have been reported in migrants to Europe. Wright- or Giemsa-stained blood smear during fever showing spirochetemia is considered diagnostic. Mortality in LBRF can be up to 5% even if treated. Treatment-induced Jarisch-Herxheimer reaction can occur.

A 17-year-old refugee from Eritrea presented with sudden fever (to 41°C), myalgias, and headache. Three days before admission, he had arrived in Switzerland after a long journey through the Sudan and Libya and across the Mediterranean and Italy. Other than mild anemia, he had unremarkable blood values (hemoglobin, 122 g/L; white blood cells, 5.6 × 109/L; platelets, 187 × 109/L) and an increased C-reactive protein of 55 mg/L. No localizing infection was found by clinical examination, chest radiograph, or urine analysis. During a search for malaria, spirochetes were spotted in the blood film (Giemsa stained, original magnification ×100). Given the travel history and clinical symptoms, louse-borne relapsing fever (LBRF) was diagnosed, caused by Borrelia recurrentis. A treatment with doxycycline for 7 days was effective.
B recurrentis is transmitted by human body lice and is endemic in the highlands of eastern Africa, southern Sudan, and the Andean foothills. The disease occurs typically in overcrowded areas and in situations with reduced hygiene like war and mass migration. In recent months, an increasing number of cases have been reported in migrants to Europe. Wright- or Giemsa-stained blood smear during fever showing spirochetemia is considered diagnostic. Mortality in LBRF can be up to 5% even if treated. Treatment-induced Jarisch-Herxheimer reaction can occur.
A 17-year-old refugee from Eritrea presented with sudden fever (to 41°C), myalgias, and headache. Three days before admission, he had arrived in Switzerland after a long journey through the Sudan and Libya and across the Mediterranean and Italy. Other than mild anemia, he had unremarkable blood values (hemoglobin, 122 g/L; white blood cells, 5.6 × 109/L; platelets, 187 × 109/L) and an increased C-reactive protein of 55 mg/L. No localizing infection was found by clinical examination, chest radiograph, or urine analysis. During a search for malaria, spirochetes were spotted in the blood film (Giemsa stained, original magnification ×100). Given the travel history and clinical symptoms, louse-borne relapsing fever (LBRF) was diagnosed, caused by Borrelia recurrentis. A treatment with doxycycline for 7 days was effective.
B recurrentis is transmitted by human body lice and is endemic in the highlands of eastern Africa, southern Sudan, and the Andean foothills. The disease occurs typically in overcrowded areas and in situations with reduced hygiene like war and mass migration. In recent months, an increasing number of cases have been reported in migrants to Europe. Wright- or Giemsa-stained blood smear during fever showing spirochetemia is considered diagnostic. Mortality in LBRF can be up to 5% even if treated. Treatment-induced Jarisch-Herxheimer reaction can occur.
For additional images, visit the ASH IMAGE BANK, a reference and teaching tool that is continually updated with new atlas and case study images. For more information visit http://imagebank.hematology.org.
This feature is available to Subscribers Only
Sign In or Create an Account Close Modal